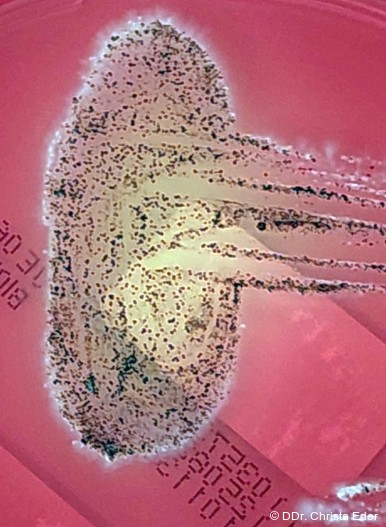

Prophylaxe 24.04.2026
Malnutrition im Senium Ursache und Folge dieser Störung im oralen Mikrobiom
share
Die Zusammensetzung dieser Mikrobiome ist in den unterschiedlichen Lebensphasen wesentlichen Veränderungen unterworfen. Das geriatrische Syndrom beschreibt die mit dem natürlichen Alterungsprozess einhergehenden physiologischen Abbauprozesse.22 Mit zunehmendem Alter nimmt die Immunkompetenz ab, zusätzlich triggern veränderte Ernährungsgewohnheiten einen Shift im oralen Mikrobiom in Richtung Artenverarmung und Überhandnehmen potenziell pathogener Erreger. Ursachen dafür sind neben einer inadäquaten Nährstoffaufnahme auch Zellalterung, Veränderungen der Zellkommunikation und der Genexpression, epigenetische Parameter und mitochondriale Dysfunktion.25
Mangelnde Kaufunktion schränkt die Ernährungsvielfalt ein
Ein häufiges Problem alter und pflegebedürftiger Personen ist die durch unterschiedliche Faktoren bedingte Fehl- oder Mangelernährung aufgrund einer gestörten, unzureichenden Mastikation.5 Der Mund ist der erste Abschnitt des Verdauungssystems. Zerkleinerung, Einspeichelung des Nahrungsbolus und Schluckvorgang sind Voraussetzungen für eine optimale Verdauung.10 Die im Alter zunehmenden chronisch entzündlichen Erkrankungen des Zahnhalteapparats, periapikale Entzündungen und Karies führen zu einer Reduktion der natürlichen Kaufunktion und letztendlich zum Zahnverlust (Abb. 1). Bei einer Restbezahnung unter 20 ist die Kaueffizienz signifikant beeinträchtigt. Leider verzichten viele ältere Menschen auf eine ausreichende technische Versorgung im Molarenbereich, da der Verlust dieser Zähne nicht als kosmetisches Problem angesehen wird. Zusätzlich verhindert das Fehlen korrespondierender Zähne in Ober- und Unterkiefer einen funktionalen Biss und bedingt dadurch eine Veränderung der Qualität der Ernährung. Weiche ohne Einsatz der Zähne zu zerkleinernde Speisen wie Weißbrot und Kuchen werden bevorzugt. Diese Probleme führen zu einer Atrophie der Kaumuskulatur mit Abnahme der Kieferschließkraft. Die eingeschränkte Speisenauswahl resultiert in einer Malnutrition durch Imbalance in der Aufnahme wichtiger Energieträger. Vor allem der Mangel an Proteinen führt zu Gewichtsverlust, Muskelabbau und krankhaft vermindertem BMI (Body-Mass-Index). Umgekehrt kann aber eine ausschließlich zucker- und fettreiche Kost auch zu Übergewicht bis zu Adipositas führen.1 Eine vorwiegend von Kohlenhydraten und gesättigten Fettsäuren dominierte Ernährung fördert Entstehung und Exazerbation metabolischer Dysfunktionen wie Diabetes mellitus II und Hyperlipidämie. Diese Krankheitsbilder sind eng mit einer Dysbiose des oralen Mikrobioms und den daraus resultierenden parodontalen und mukosalen Erkrankungen assoziiert (Abb. 2).9, 13
Orale Entzündungen verändern Resorption und Eiweißprofil
Inflammationen wie Parodontitis und Stomatitis koppeln ihrerseits negativ auf die Nahrungsverwertung und den bereits angegriffenen Proteinmetabolismus zurück. Es kommt zu signifikanten Veränderungen in der Expression typischer Biomarker des Ernährungsprofils wie Serumalbumin, Präalbumin, Transferrin, Retinol-Bindungsprotein sowie der für Malnutrition typischen Aminosäurenprofile (vor allem Tryptophan, Tyrosin und Phenylalanin). Das Defizit an Eiweiß schwächt die im Alter an sich schon verminderten Abwehrkräfte, ein unter dem Begriff Immunseneszenz bekanntes Phänomen.21 Der Seneszenz-assoziierte sekretorische Phänotyp (SASP) geht mit einer erhöhten Bereitschaft zu chronischen Entzündungen mit anhaltender erhöhter Sekretion von Zytokinen, Chemokinen und Wachstumsfaktoren durch überalterte Zellen einher.23
Durch Mangelernährung verminderte Zufuhr von Vitaminen, Mineralien und Spurenelementen beeinträchtigt zusätzlich sowohl die orale als auch die systemische Gesundheit. Eine zu geringe Aufnahme von Vitamin A schwächt die Schleimhautbarriere, Vitamin-C-Mangel erhöht die Infektanfälligkeit, Defizite an den Vitaminen B1 und B12 gehen mit Appetitlosigkeit, Müdigkeit, Sensibilitätsstörungen und mitochondrialer Dysfunktion einher. Es fehlen entzündungshemmende Antioxidantien, sowie Eisen und Kalzium.2
Diese Faktoren beeinträchtigen nicht nur die Integrität der oralen Gewebe, sie modulieren auch signifikant das orale Mikrobiom. Im gesunden Zustand dominieren in der Mundflora grampositive Keime. Viele dieser bakteriellen Spezies gehören zur Residentflora und schützen als solche die ökologischen Nischen der Mundhöhle vor der Etablierung pathogener Arten. Mangelernährung führt in Korrelation mit einem zu niedrigen BMI zu einem Verlust dieser Normalflora mit einer massiven Zunahme virulenter Mikroorganismen. Opportunistische oralpathogene Bakterien wie Porphyromonas gingivalis, Tannerella forsythia, Prevotella intermedia, aber auch primär nicht orale Keime wie Escherichia coli, Klebsiella und Eitererreger wie Staphylococcus aureus nehmen aufgrund gestörter Antigenpräsentation und Antikörperbildung überhand. Die in Biofilmen organisierten Erreger führen zu Genese und Exazerbation gingivaler und parodontaler Inflammationen und darüber hinaus zu einer systemischen Erhöhung von Entzündungsmarkern wie TNF-α, Interleukin 6 (IL-6) und C-reaktivem Protein (CRP).3, 17
Speichelmangel im Alter fördert pathogene Mikroorganismen
Hyposalivation und die daraus resultierende Xerostomie zählen zu den häufigsten Problemen älterer Patienten. Verminderte Flüssigkeitsaufnahme, die Nebenwirkungen multipler Dauermedikationen und altersbedingte Atrophie des Parenchyms der Glandulae salivariae verändern das orale Mikroökosystem.6 Der fehlende protektive Pellikel aus Speichelproteinen macht die Mundschleimhaut und die Gingiva vulnerabel und anfällig für Verletzungen. Die damit einhergehenden geringfügigen Blutungen sind wiederum ein idealer Nährboden für parodontalpathogene Bakterien wie die schwarzpigmentierten Anaerobier (Abb. 3). Eine eingeschränkte Spülfunktion, das Absinken des intraoralen pH-Werts durch verminderte Pufferwirkung und das Fehlen antibakterieller Komponenten wie IgA und Lysozym ermöglichen die Etablierung komplexer supra- und subgingivaler Biofilme. Die Xerostomie verursacht neben appetitreduzierenden Geschmacksveränderungen auch Probleme beim Einspeicheln der Nahrung und beim Schluckvorgang.12
Transformation der Mundflora bei Prothesenträgern
Teil- oder Vollprothesen haben die Aufgabe, Zahnverlust zu kompensieren und die Kaufunktion zumindest teilweise wiederherzustellen. Die artifiziellen Oberflächen in Kombination mit dem Verlust der ursprünglichen ökologischen Nischen verändern allerdings das intraorale Milieu und damit die Komposition der Mundflora. Es bestehen signifikante Unterschiede in der Zusammensetzung und Diversität der Biozönosen in Regionen mit verbliebenen eigenen Zähnen und in jenen mit künstlichem Zahnersatz.19 Bei Teilprothesen wird die Besiedlung noch stark von der umgebenden Restbezahnung beeinflusst. Im Unterschied dazu findet man beim vollständigen Zahnersatz im Bereich des Prothesenlagers ein in sich abgeschlossenes, nährstoffreiches Biotop mit Dominanz spezifischer mikrobieller Spezies. Prothesenkunststoff ist keine biologische Struktur und deshalb deutlich weniger zur lokalen Immunabwehr exponiert.7, 20 Dies ermöglicht die Entwicklung einer symbiontischen koaggregierenden Plaque. Der sogenannten Prothesenstomatitis kommt vor allem wegen ihrer Tendenz zur Chronifizierung Bedeutung zu. Gefördert wird dieser Prozess durch mögliche Druckstellen an den Auflageflächen des Zahnersatzes. Mikrobiologische Untersuchungen zeigen neben der in 30 bis 70 Prozent nachweisbaren Hefe Candida albicans eine Zunahme von Actinomyceten, Atobium und Anaerobiern aus den Gruppen Bacteroidea und Prevotella (Abb. 4). Gleichzeitig sind Vertreter einer gesunden Flora wie Streptococcus sanguis und Streptococcus gordonii stark reduziert.14
Die Achse zwischen Mund und Gastrointestinaltrakt im Alter
Candidaspezies sind in geringer Dichte auch in einem gesunden Mikrobiom vertreten. Bei Störung des biologischen Gleichgewichts wird allerdings aus dem Kommensalen ein Pathobiont. Als aktiver Biofilmbildner verfügt die für 80 Prozent der oropharyngealen Candidosen verantwortliche Candida albicans über spezielle Adhäsine und Invasine, welche ihr ermöglichen, die Epithelschranke zu überwinden und schmerzende Erosionen der Mundschleimhaut zu verursachen. Zusätzlich greift die orale Infektion nicht selten auf die Speiseröhre über und führt dort zu einer Sooroesophagitis mit den typischen Symptomen einer Odynophagie mit Bolusgefühl und retrosternalem Brennen. Ältere Menschen leiden oft unter einer Sphinkterschwäche des Magens und gastrooesophagealem Reflux (GERD). Der aufsteigende saure enzymhaltige Magensaft verursacht Läsionen sowohl am Epithel der Speiseröhre als auch auf der oralen Mukosa und begünstigt damit eine Candidiasis an beiden Lokalisationen.
Damit einhergehende Beschwerden machen eine normale ausgewogene Ernährung nahezu unmöglich.15, 16 Die veränderte, nun pathogene Mundflora hat aber auch Einfluss auf sämtliche weitere Verdauungsschritte. Über den mikrobiell kontaminierten Speichel geraten Hefen und Bakterien in sämtliche Abschnitte des Gastrointestinaltrakts. Sowohl Candida als auch virulente Bakterien wie Porphyromonas gingivalis können problemlos die Säureschranke des Magens überwinden. Sie triggern chronische Entzündungen und Metaplasie der Magenschleimhaut (Abb. 5) und können sich danach im Dünn- und Dickdarm in das präexistente Mikrobiom integrieren.11 Als sogenannte „keystone Organismen“ mit selbst nur geringer Reproduktionsrate modulieren sie das Darmmilieu in Richtung eines dysbiotischen Mikrobioms.18 Orale Pathogene wie Fusobacterium nucleatum und Porphyromonas gingivalis sind maßgeblich an der Induktion dysplastischer Epithelveränderungen und an der Progression der Adenom-Karzinomsequenz im Colon beteiligt (Abb. 6). Die Artenverarmung und das Ungleichgewicht innerhalb der Darmflora werden durch eine im Alter oft unzureichende Aufnahme von faserreicher Kost gefördert. Ballaststoffe sind aber wesentlich, weil die Bakterien daraus kurzkettige Fettsäuren wie das stoffwechselfördernde Acetat, das entzündungshemmende Propionat und das die Darmbarriere stärkende Butyrat synthetisieren. Ein Ballaststoffmangel führt zu Resorptionsstörungen und lokaler Immundefizienz.2 Die Auswirkungen von altersbedingten Mastikationsstörungen und Zahnverlust gehen weit über ausschließlich orale Probleme hinaus. Schwerwiegende Folgen wie Malnutrition und die Progression systemischer und metabolischer Erkrankungen machen die Alterszahnmedizin zu einer wichtigen Disziplin für die Gesundheit im Senium. Die Erhaltung und Reetablierung einer artenreichen gesunden Mundflora, frühzeitige Intervention bei fungalen und bakteriellen Entzündungen und im Bedarfsfall optimale prothetische und technische Versorgung zur Wiederherstellung der Kaufunktion sind Eckpfeiler einer gesunde Ernährung im höheren Alter.